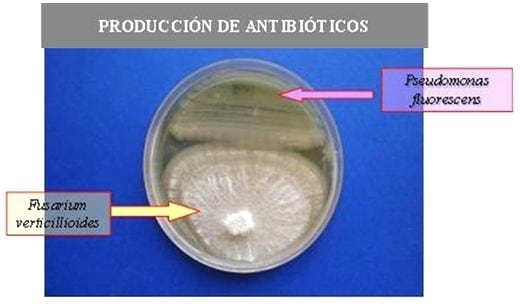
Uso de Bacterias Promotoras del Crecimiento Vegetal, Inoculantes en el cultivo de Maíz - Image 3

Sr Salazar en respuesta a sus consultas, la supervivencia de las bacterias en el envase contenedor es de 180 días debido al desarrollo de un medio de cultivo especifico con el cual viene formulado el producto además de esto la presentación comercial cuenta con un protector bacteriano externo cuyas funciones son la de proteger, adherir y nutrir a la bacteria, el mismo se mezcla junto con el inoculante al momento de realizar el tratamiento sobre la semilla.


Sr Pedro Guitron Partida le comento que tenemos evaluado la compatibilidad del producto con un gran número de principios activos que se utilizan normalmente para el tratamiento de semillas, tanto fungicidas como insecticidas, con muy buenos resultados. En cuanto a la secuencia de tratamiento, lo recomendable es tratar la semilla con el producto químico, dejar orear y luego aplicar el inoculante.
Nuestras experiencias con este producto son fundamentalmente sobre cultivos extensivos como maíz y trigo como experiencia en hortalizas puedo comentarle ensayos sobre lechuga cultivada en hionia donde logramos un mayor desarrollo radicular y una reducción de 8 días en la etapa de crecimiento de la misma.
Estimado Marco, en respuesta a sus preguntas, la presentación del producto es de un sobre de inoculante (preparado con las bacterias) más un protector bacteriano la dosis de uso es de 50 ml de inoculante mas 20 ml de protector cada 10 kg de semilla de maíz. Ambos se mezclan al momento de realizar el tratamiento y juntos se aplican sobre la semilla. En cuanto a los tiempos de almacenamiento la recomendación es de tratar la semilla y sembrar dentro del mismo día.




Colega estos tipos de trabajos debemos de seguir difundiendolo, debido a que he probado esta bacteria en los campos de INIA -Vista Florida -Lambayeque Peru. y se han obtenido los siguientes resultados :
a) se incremento el rendimiento del maíz en 10[percent] cuando se uso solo las bacterias solas, versus el testigo que no utilizo Fosforo.
b) No se encontraron diferencias significativas entre el maíz con bacterias solas y el testigo que utilizo fosforo.
c) Actualmente esta siendo evaluada en campo de maiz esta bacteria y se continua con las evaluaciones respectivas.
Esperando continuar en futuro con ustedes en otro trabajos en nuestros campos de investigación.
Pedro Injante
Jefe de Investigación en Cultivos - INIA Vista Florida
Lambayeque - Perú
APRECIADO COLEGA GUSTAVO GONZALES:AUNQUE TIEMPO ATRAS HABIA PARTICIPADO EN ESTE EXCELENTE ARTICULO SOBRE BACTERIAS PROMOTORAS DEL CRECIMIENTO VEGETAL, INOCULANTES EN EL CULTIVO DE MAÍZ. ME QUEDA POR PREGUNTARLE QUIEN DISTRIBUYE EN COLOMBIA ESTOS EFICIENTES MICROORGANISMOS Y MUCHOS OTROS PRODUCTOS DE SU LINEA FIN CONTACTARLO.
MIL GRACIAS:
MARCO TULIO OSORIO S I.A
